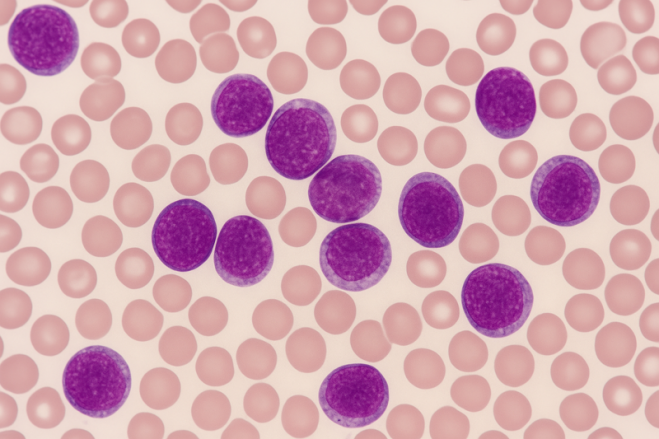
图片

本文由盛诺一家原创编译,转载需经授权
摘要
近日,在2025年美国血液学会年会上公布的1期KOMET-007试验的结果显示:将Ziftomenib(商品名Komzifti)与Venetoclax和Azacitidine联合使用,在携带NPM1突变或KMT2A重排的复发或难治性成人急性髓系白血病(AML)患者中耐受性良好,并表现出显著的临床活性。
来源:ChatGPT生成AI示意图
疗效数据
在NPM1突变组中:
客观缓解率(ORR)为65%,意味着有65%的患者在治疗后白血病细胞明显减少或消失,病情出现实质性好转。
综合完全缓解率(CRc)为48%,意味着有48%的患者病情达到完全或接近完全缓解,血液和骨髓中的癌细胞几乎消失。
其中有27%的患者达到了完全缓解(CR)伴完全血液学恢复,意味着有27%的患者白血病细胞清除且血液指标恢复正常。
其中有13%的患者达到了完全缓解(CR)伴部分血液学恢复,意味着有13%的患者虽已缓解但血液功能尚未完全恢复。
其中有8%的患者达到了完全缓解(CR)伴不完全的血液学恢复,意味着有8%的患者虽主要癌细胞已消失,但血液恢复仍不完全。
最小残留病灶阴性率(MRD阴性率)为60%,意味着有60%的患者在治疗后体内已检测不到任何可测的白血病细胞,说明治疗效果更彻底,复发风险更低。
首次达到最小残留病灶阴性(MRD阴性)的平均时间为8.8周,意味着多数患者在治疗后大约8.8周时,体内已检测不到白血病细胞,显示治疗起效较快。
综合完全缓解持续时间的中位数为39.9周,意味着多数患者在达到病情完全缓解后,能够维持约39.9周的稳定状态而不出现复发。
平均总生存期为54.9周。
在KMT2A重排组中:
客观缓解率(ORR)为41%,意味着有41%的患者在治疗后白血病细胞明显减少或消失,病情出现实质性好转。
综合完全缓解率(CRc)为28%,意味着有28%的患者病情达到完全或接近完全缓解,血液和骨髓中的癌细胞几乎消失。
其中有41%的患者达到了完全缓解(CR)伴完全血液学恢复,意味着有41%的患者白血病细胞清除且血液指标恢复正常。
其中有6%的患者达到了完全缓解(CR)伴部分血液学恢复,意味着有6%的患者虽已缓解但血液功能尚未完全恢复。
其中有16%的患者达到了完全缓解(CR)伴不完全的血液学恢复,意味着有16%的患者虽主要癌细胞已消失,但血液恢复仍不完全。
最小残留病灶阴性率(MRD阴性率)为43%,意味着有43%的患者在治疗后体内已检测不到任何可测的白血病细胞,说明治疗效果更彻底,复发风险更低。
首次达到最小残留病灶阴性(MRD阴性)的平均时间为8.1周,意味着多数患者在治疗后大约8.1周时,体内已检测不到白血病细胞,显示治疗起效较快。
综合完全缓解持续时间的中位数为12.4周,意味着多数患者在达到病情完全缓解后,能够维持约12.4周的稳定状态而不出现复发。
平均总生存期为21.1周。
安全性数据
该研究的安全性数据显示:
试验中接受治疗的患者中(共83名),有98%出现了治疗相关不良事件(TEAEs),其中NPM1突变组(共51名)为96%,KMT2A重排组(共32名)为100%。
所有患者中最常见的不良事件包括恶心(41%)、疲劳(37%)、血小板减少(36%)、发热性中性粒细胞减少(33%),以及腹泻、白细胞减少和中性粒细胞减少(各31%)。
与Ziftomenib直接相关的最常见不良事件包括恶心(16%)、疲劳和皮肤瘙痒(各15%),以及血小板减少、发热性中性粒细胞减少、中性粒细胞减少和贫血(各10%)。
此外,所有患者中严重的3级或以上不良事件的发生率为92%,其中NPM1突变组为90%,KMT2A重排组为94%。
最常见的3级或以上不良事件包括血小板减少(34%),发热性中性粒细胞减少、白细胞减少、中性粒细胞减少(各31%)和贫血(21%)。
与Ziftomenib相关的3级或以上不良事件主要包括发热性中性粒细胞减少和中性粒细胞减少(各10%)、血小板减少和白细胞减少(各8%)以及贫血(7%)。
在这些组别中没有观察到与Ziftomenib相关的QTc间期延长(指心脏电活动恢复时间变得比正常更长,可能导致心律失常甚至猝死的风险增加),且仅有2%的患者因药物相关不良事件停药:一例为4级脓毒症,另一例为3级口腔炎,均出现在KMT2A重排组。
试验详情
在正在进行的1期KOMET-007试验(临床试验注册号NCT05735184)中,患者在剂量递增阶段接受Ziftomenib联合Venetoclax和Azacitidine治疗,剂量从200mg逐步增加到600mg。
在1b期的推荐2期剂量确认阶段,患者接受600mg Ziftomenib联合Venetoclax和Azacitidine治疗。Azacitidine在第1个治疗周期的第1至第7天给药,后续周期根据骨髓活检结果调整;Venetoclax按照说明书规定的方案,在每个28天为一个周期的疗程中给药,周期长度可根据骨髓活检结果调整。
试验的主要终点包括完全缓解率和不良事件。次要终点包括缓解持续时间、客观缓解率、综合完全缓解率和MRD阴性率。
专家评论
“在持续进行的KOMET-007研究中,每日一次600mg剂量的Ziftomenib联合Venetoclax和Azacitidine治疗,在复发或难治性NPM1突变或KMT2A重排AML患者中耐受性良好。Ziftomenib相关的骨髓抑制发生率很低,没有观察到QTc间期延长,仅报告了一例分化综合征。这是一位携带NPM1突变的患者出现的3级事件,按照方案要求成功管理,患者随后得以继续使用Ziftomenib。”美国麻省总医院白血病中心项目主任、哈佛医学院副教授Amir T. Fathi博士在会议报告中表示。
关于Ziftomenib
Ziftomenib所属公司为美国Kura Oncology公司,是一种menin抑制剂。
基于1/2期KO-MEN-001试验(临床试验注册号NCT04067336)的结果,Ziftomenib已于2025年11月13日获得美国食品药品监督管理局(FDA)批准,用于治疗复发或难治性NPM1突变型急性髓系白血病(AML)患者。
资料来源:
https://www.cancernetwork.com/view/ziftomenib-combo-exhibits-tolerability-early-activity-in-npm1-kmt2a-aml
【盛诺一家】成立于2011年,是国内领先的海外医疗咨询服务机构,至今已为近10000个患者家庭提供出国就医服务,重点涵盖癌症、心脏病、罕见疾病等重疾领域。凭借专业、贴心、高效的服务,盛诺一家赢得了99%客户好评率!
📌为什么出国就医患者选择盛诺一家?
- 官方资质:与美国、日本、英国近50家TOP级医院签署官方合作协议,搭建全球医疗服务网络
- 专业可靠:咨询服务团队成员70%拥有医学背景,包括医学院博士、三甲医院医生、资深医学翻译
- 一站式服务:在全球设有15个客户服务中心,保障从国内到海外全流程、高品质的服务质量
- 客户至上:推出48小时冷静期、风险告知书、医疗费用“零加成”等措施,保障客户权益
- 专属折扣:通过本公司预约出国就医的患者,可额外申请5%–40%的医疗费用减免折扣
👉如果您或者家人需要出国看病,可拨打免费咨询热线 400-855-7089,或通过 盛诺一家官网 预约咨询!



